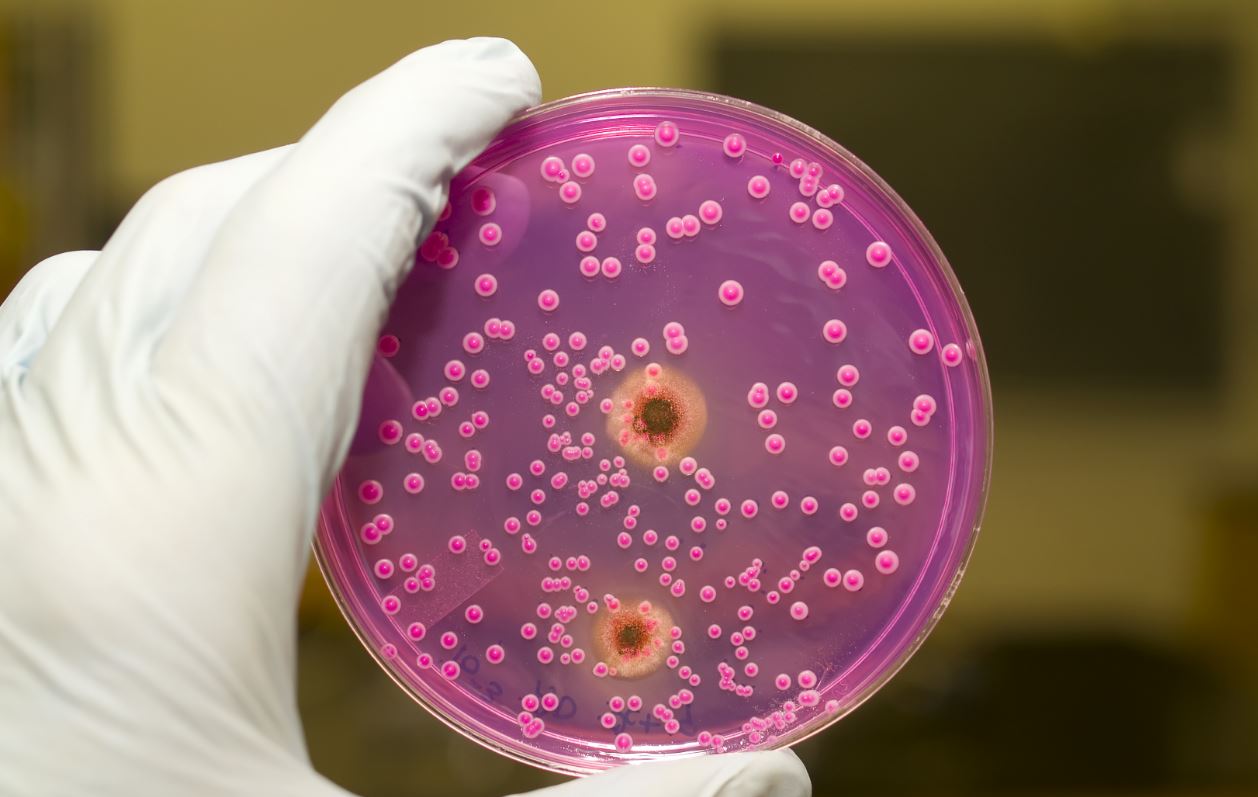

Candida insanlar ve hayvanlar üzerinde görülmekte olan mantarların neden olduğu bir maya türüdür. Candida mantarı vücudumuzun her noktasında oluşabilir. Belli nedenlere bağlı olarak oluşmaktadır. Özellikle sıcak ve nemli ortamlarda mantar üremesine meyilli olduğu zamanlarda daha kolay oluşma gösterir. Bu mantarların oluşturdukları enfeksiyonlar arasında vajinal bölgede gerçekleşen enfeksiyonu da vardır. Bunun dışında pamukçuk, isilik, tırnak yatağı enfeksiyonu ve göğsü büyük olan kişilerin göğüz alt kısımlarında meydana gelmektedir. Bebeklerde Candida mantarı daha sık görülür. Bebekler mantar oluşumuna daha meyilli bir bünyeye sahiptir. Vajinal mantarların adı vajinal kandidiyazis olarak da bilinir. Yetişkinlerde enfeksiyon ve mantar oluşumunda artış yaşanır fakat bu oran yaşlılarda daha çok ortaya çıkar.
Candida Mantarı Nedir?
Candida Albicans mantar türü, hayatımızda karşılaştığımız birçok hastalığın nedeni olabilmektedir. Adet düzensizliği, egzama, fazla kilo ya da depresyon gibi hastalıkların temelini oluşturabilmektedir. Bu hastalıktan kurtulmak için diyet en başarılı yöntemdir. Diyet Candida mantarının vücuttan arındırılmasında önemli bir rol oynamaktadır. Candida mantarı maya mantarıdır. Hücreye konak halinde girdikten sonra tomurcuklanma yaparak çoğalma gösterir.
Candida mantarı ağız, bağırsak, vajina, üst solunum yolları ve deri üzerinde sık görülür. Bağışıklık sisteminiz güçsüz düştüğü zaman birçok hastalığa zemin hazırladığını biliyoruz. Candida da bağışıklık sisteminin kötü etkilendiği durumlarda yüzeysel ya da derinlemesine bir mantar enfeksiyonu oluşumunu tetikleyebilmektedir. Ağız da sık görülen bir mantar çeşididir. Pamukçuk olarak adlandırdığımız dil üstünde ve ağızın belli noktalarında pamuk gibi beyaz oluşumlar bu mayadan kaynaklanır. Vajina bölgesinde, oniko mikozlarda yani tırnak, koltukaltı, göğüs çevresinde oluşmaya oldukça meyillidir.
Islak ve nemli bölgeleri çok sevdikleri için bu bölgelerin nemli kalması enfeksiyon ve mantar oluşumunu tetiklemektedir. Candida mantarı ileri bir enfeksiyona neden olmuş ise bağışıklık sisteminizde ciddi bir zayıflama meydana gelebilir. Bu zayıflayan bağışıklık sistemi ile birlikte endokardir, menenjit, beyin apsesi, piyelonefrit ve sistit oluşu görülebilir. Karaciğer ve böbrek hastalıklarında lösemi (kan kanseri) ve yaşlılar da bu enfeksiyon böbrek yetmezliği sorunun meydana gelmesine neden olabilir. Bebeklik dönemlerinde pişik sorunu oldukça sık görülür. Bu da Candida mantarından kaynaklı oluşabilir.
Antibiyotik ve steroid kullanımlarında Candida mantarı çoğalma gösterebilir. Hamilelik dönemi, diyabet ya da doğum kontrol ilaçları mantar enfeksiyonunun oluşmasına neden olmaktadır. Menopoz sonrasında da Candida mantarı oluşumu oldukça sık görülür. Bağışıklık sisteminin zayıflaması sonucunda kanser ve ya AIDS gibi sağlık sorunları oluşmakta. Bu durumlarda da Cansisa mantarı oluşması için uygun bir ortam oluşmuş olur. Bağışıklık sistemi zayıf olan insanlar zaten sık sağlık problemleri ile karşılaşırlar. Özellikle hastaların kullandığı idrar sondaları, vücuda bağlanan cihazların ve ya tüplerin mantar enfeksiyonunu tetiklediği tespit edilmiştir. Kullanılan tıbbi malzemelerin de temiz olmaması Candida mantarına neden olmaktadır.
Candida Mantarı Belirtileri
Candida mantarı nemli ve sıcak bölgeleri sevmektedir. Özellikle terlemeye meyilli olan ve nefes alamayan noktalar da bu mantar enfeksiyonuna kapı aralamaktadır. Candida mantar enfeksiyonu yaşayan hastalarda belli başlı belirtiler görülür. Kadınlarda görülen belirtilerde genellikle vajinal mantar enfeksiyonlarıdır. Bu bölgelerde genellikle beyaz akıntılar meydana gelmektedir. Bu bölgede oluşmuş enfeksiyonlar kaşıntıya neden olduğu gibi bu bölgenin tahriş olmasını tetikler. İdrar yaparken de yanma hissi uyandırabilir. Erkeklerde ise bu mantar enfeksiyonu belirtilerinde kadınlara benzer şekilde genital mantar enfeksiyonundan kaynaklı olabilir. Özellikle kadınlarla cinsel temas sağladıktan sonra bu mantar enfeksiyonun oluştuğu görülür. Erkeklerin cinsel organlarında yanma ve dökülme sorunları yaşanır.
Bebeklerde ise, Candida mantarına oral kandidiyazis pamukluk denilir. Çünkü bebelerde bu mantar ağız içi enfeksiyon şeklinde gelişir. Bebeklik dönemlerinde pamukçuk çok sık rastlanan bir durumdur. Bu bebeğinizin yemek yemesini ya da emmesini zorlaştırabilir çünkü ağrı duymasına neden olacaktır. Pamukçuk enfeksiyonu oluşmuş ise bu bölge bol su ile çalkalanmalıdır. Nemli bölgelerde de bebeklerde mantar enfeksiyonları görülür. Bunlar bebeklerde en çok bez kullanım döneminde yaşanır. Bebeklerinizin tuvaletini yaptıktan sonra bezlerini hemen değiştirmeniz önemlidir. Bağışıklık sistemi zayıflamış bireyler her türlü dış etkene açık konumdadır. Kanser ve AIDS gibi ciddi bağışıklık sorunu hastalıkları yaşayan hastalarımız Candida mantar enfeksiyonu yaşayabilirler. Bu mantar türü bağışıklık sistemi zayıflıklarını çok sever. Bu mantarlarda iç organlarınızı etkileyebilir. İç organlarına yayılma göstereceği için ateş yükselmesi, mide bulantısı ve devamında kusma, göğüs bölgesinde ağrı yaşanması gibi belirtileri oluşturabilir.
Candida Mantarı Diyeti
Vücudunuz da Candida mantarı bulunuyorsa öncelikle bağışıklık sisteminizi geliştirmeniz önemli olacaktır. Öncelikle mantarın oluşumuna neden olan mantarın oluşumunu öldürmek gerekecektir. Bunun için yemek içmemize dikkat etmemiz gerekebilir. Bunun için bir diyet programı hazırlanabilir. Bu mayanın oluşmasına neden olabilen besinlerin tüketilmesinden kaçınmalıdır. Kişi kendisini iyi gözlemlemiş ise yediği besinlerden bünyenin verdiği tepkileri bilmektedir. Bunun dışında bir sağlık kuruluşunda da tükettiği besinlerin vücuduna zarar verip vermediğine baktırabilir. Bu sorunlara bağlı bir diyet daha doğrusu mantarı engellemeye yarayacak yeme programı hazırlanabilir. Oluşturacağınız bu düzenli beslenme yani diyet programında sebze, tam tahıllı besinler ve bitkisel temelli ve protein içerikli olmalıdır. Tüketeceğiniz tahılları ve sebzeleri sarımsak, fesleğen, tarhun otu ya da çeşitli baharatlar ile tatlandırabilirsiniz. Tam tahıllı besinleri tüketmeye ağırlık veriniz. Çünkü tam tahıl şeker emilimine yardımcı olur. Meyve tüketmek de faydalı olacaktır. Bağışıklık sistemi güçlendirmek açısından şeker emilimi hızlandırıcı maddeler tüketmek yararlı olur.
Candida Mantarı Testi Nasıl Olur?
Candida mantar testini bir doktor yardımı alarak sağlık kuruluşlarını yapabilirsiniz. Bunun dışında basit bir test olduğundan dolayı evde de yapabilirsiniz. Sabah uyandığınız zaman hiçbir şey yiyip içmeden, temiz bir bardağa içme suyu doldurunuz. İçme suyunun oda sıcaklığında olduğuna dikkat ediniz. Ağzınızda bir miktar tükürük biriktirin ve doldurduğunuz bardağın içine tükürünüz. Suyu 1 saat boyunca her 15 dakika da bir izleyiniz. Eğer ki bu su üzerinde bulunan tükürük aşağı doğru lif gibi sarkıyor ise, suyun içerisinde torular yüzüyor ise ya da bu tortu görünümünde ki tükürük dibe çökmüş ise Candida mantarı sorunu olabilir.
Candida Mantarı Bitkisel Tedavisi
Candida mantarının tedavisi uzun bir süre ister. Tedavi süreci ile diyet ile birlikte desteklenmelidir. Protein ve tam tahıl ağırlıklı bir beslenme programı oluşturulmalıdır. Sebzelerin ve meyvelerin iyice yıkanarak tüketilmesi oldukça önemlidir. Tuvalet alışkanlıklarınızda ve dışarı da kullandığınız bu tür alanlarında temizliğine dikkat ediniz. Modern tıptan ziyade bitkisel tedavi çeşitleri de bu mantar türlerinde işe yarayabilmektedir. Tedavi sürecinde antibiyotikler ve hormon ilaçları olumsuz etki oluşturabilir. Portakal nergisi ve çörek otu tohumu yağı oldukça etkilidir. Kaynatılan temiz ve klorsuz bir içme suyuna bir tatlı kaşığı kadar portakal nergisi ekliyoruz.
Kısık ateşte bir süre kaynamaya bırakıyoruz. Kaynatılan bu kür süzülüyor ve ılıdığı zaman akşam yemeğinden 2 saat kadar sonra içilmesi gerekiyor. Uyuyana kadar bir şey yenmemesi gerekiyor. Bu hazırlanan kür içildikten 2 saat kadar sonra bir emek kaşığı kadar çörek otu tohumu yağı içilmelidir. Bu kür 1 ay süre ile yatmadan önce uygulanmalıdır. Her gün taze bir şekilde hazırlanmalıdır. Bu kürün dışında sarımsak ve elma sirkesi tüketmekte oldukça etkilidir. Bağırsaklarınızı temizleyeceği gibi bağışıklık sisteminizi de güçlendirmeye yarayacaktır. Baharatlı yemekler yemekte sizin için iyi bir tedavi yöntemi olabilir.
Candida Mantarı İbrahim Saraçoğlu Tavsiyeleri
İbrahim Saraçoğlu Candida mantarları için aynısafa bitkisini tüketilmesi tavsiyesinde bulunuyor. Aktarlardan kolaylıkla bulabileceğiniz bu bitkiyi her akşam kaynatmanızı önermekte. 8 dakika kadar kaynattığınız bu suyu ılımaya bırakınız ve içiniz. İbrahim Saraçoğlu bu önerdiği kürü gün içerisinde iki defa ve 1 ay süre ile tüketilmesini söylüyor. Bu tür bitkisel kürlerin taze olarak her ün hazırlanması önemlidir. Eğer bu kürü düzenli olarak uygularsanız bağırsaklarınızı temizleyerek mantar oluşumuna çözüm olacaktır.
Candida Mantarı Tedavisi
Candida tedavisinde doktorunuz enfeksiyon önleyici ve rahatlatıcı bir krem önerebilir. Bunun dışında bazı enfeksiyon ve bakteri önleyici ilaçlar tavsiye edecektir. Kremler ile bölge rahatlatılırken bedenen de mantar öldürülmeye çalışılır. Bunun yanında doktorunuz bazı vitamin desteği verebilir. Bağışıklık sisteminin güçlenmesi için.